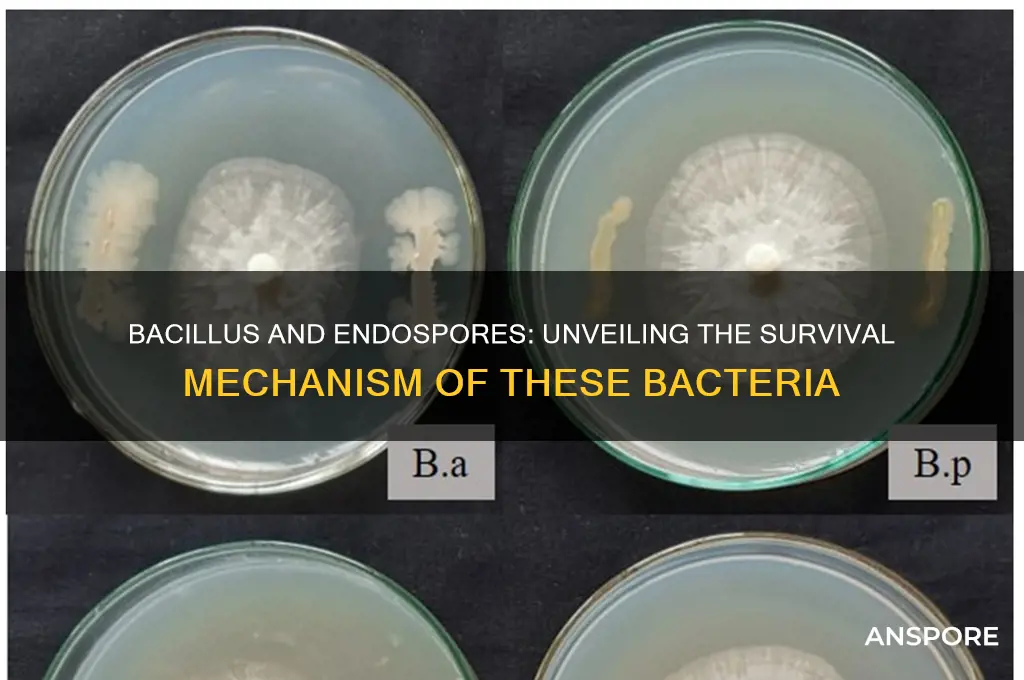
does bacillus have endo spores

Bacillus, a genus of Gram-positive, rod-shaped bacteria, is widely recognized for its ability to form endospores, which are highly resistant, dormant structures produced under unfavorable environmental conditions. These endospores allow Bacillus species to survive extreme temperatures, desiccation, and exposure to chemicals, making them ubiquitous in diverse habitats such as soil, water, and even the gastrointestinal tracts of animals. The formation of endospores is a key characteristic that distinguishes Bacillus from many other bacterial genera and plays a crucial role in their ecological success and applications in biotechnology, including food production and bioremediation. Understanding the presence and function of endospores in Bacillus is essential for studying their survival strategies and harnessing their potential in various industries.
| Characteristics | Values |
|---|---|
| Endospore Formation | Yes, Bacillus species are known for their ability to form endospores. |
| Endospore Location | Endospores are formed within the bacterial cell, typically in the center or at one end. |
| Endospore Function | Endospores serve as a survival mechanism, allowing Bacillus to withstand harsh conditions such as heat, radiation, and desiccation. |
| Endospore Structure | Endospores consist of a core containing DNA, ribosomes, and enzymes, surrounded by a cortex, spore coat, and sometimes an exosporium. |
| Endospore Resistance | Highly resistant to extreme temperatures, UV radiation, chemicals, and enzymes. |
| Endospore Germination | Endospores can germinate and return to vegetative growth when favorable conditions return. |
| Species with Endospores | All Bacillus species, including Bacillus anthracis, Bacillus cereus, and Bacillus subtilis, form endospores. |
| Endospore Detection | Detected through staining techniques like the Schaeffer-Fulton stain, which highlights endospores as green against a red background. |
| Endospore Size | Typically smaller than the vegetative bacterial cell, ranging from 0.5 to 1.5 μm in diameter. |
| Endospore Lifespan | Endospores can remain viable for years, even decades, under unfavorable conditions. |
Explore related products
What You'll Learn
- Endospore Formation Process: Bacillus species form endospores under stress via sporulation
- Endospore Structure: Endospores have a core, cortex, and protective layers for survival
- Endospore Function: Endospores ensure bacterial survival in harsh conditions like heat and drought
- Endospore Germination: Endospores return to vegetative state when favorable conditions return
- Bacillus Species Variation: Not all Bacillus species produce endospores; depends on the strain

Endospore Formation Process: Bacillus species form endospores under stress via sporulation
Bacillus species, renowned for their resilience, employ a remarkable survival strategy: endospore formation. This process, known as sporulation, is triggered by environmental stressors such as nutrient depletion, desiccation, or extreme temperatures. Unlike vegetative cells, endospores are highly resistant to heat, radiation, and chemicals, allowing Bacillus to endure harsh conditions for extended periods. Understanding this mechanism not only highlights the adaptability of these bacteria but also underscores their significance in fields like biotechnology and medicine.
The sporulation process in Bacillus is a complex, multi-stage transformation. It begins with the asymmetric division of the bacterial cell, forming a smaller cell (forespore) within the larger mother cell. This is followed by the engulfment of the forespore, where the mother cell’s membrane surrounds it, creating a double-layered structure. Subsequently, the forespore matures through the deposition of protective layers, including a thick peptidoglycan cortex and a proteinaceous coat. Finally, the mother cell lyses, releasing the fully formed endospore. This intricate process ensures the endospore’s durability, enabling it to remain dormant until favorable conditions return.
From a practical standpoint, the endospore formation process has significant implications. For instance, in food preservation, Bacillus endospores pose a challenge due to their resistance to conventional sterilization methods. To effectively eliminate them, industries often employ high-pressure processing or temperatures exceeding 121°C for at least 15 minutes. Conversely, in biotechnology, endospores are harnessed for their stability, serving as vectors for enzyme production or vaccine delivery. Understanding sporulation thus allows for both mitigation of risks and optimization of benefits.
Comparatively, the sporulation process in Bacillus stands out among bacterial survival strategies. While other bacteria may form cysts or biofilms, endospores offer unparalleled resistance. For example, Clostridium species also form endospores, but Bacillus endospores are more heat-resistant, surviving temperatures up to 140°C. This distinction makes Bacillus a model organism for studying extremophile adaptations and a target for developing antimicrobial strategies.
In conclusion, the endospore formation process in Bacillus species is a fascinating example of microbial ingenuity. By undergoing sporulation under stress, these bacteria ensure their survival in adverse environments. Whether viewed through a scientific, industrial, or comparative lens, this mechanism offers valuable insights and practical applications. For researchers, clinicians, and industry professionals, understanding sporulation is key to both combating and leveraging the resilience of Bacillus.
Does Rain Increase Mold Spores? Understanding the Link Between Rain and Mold
You may want to see also

Endospore Structure: Endospores have a core, cortex, and protective layers for survival
Bacillus species are renowned for their ability to form endospores, a critical survival mechanism that allows them to withstand extreme environmental conditions. At the heart of this resilience lies the intricate structure of the endospore, which consists of a core, cortex, and multiple protective layers. Each component plays a distinct role in ensuring the organism’s longevity, even in the harshest environments. Understanding this structure is essential for fields ranging from microbiology to biotechnology, as it highlights nature’s ingenuity in preserving life.
The core of the endospore is the most vital region, housing the bacterium’s genetic material and essential enzymes in a dehydrated state. This dehydration reduces metabolic activity to nearly zero, enabling the endospore to remain dormant for years, even centuries. The core’s low water content, typically around 10-25% of its dry weight, is a key factor in its stability. For comparison, a typical bacterial cell contains 80% water, making it far more susceptible to environmental damage. This extreme desiccation is achieved through the accumulation of calcium dipicolinate, a small molecule that binds water and stabilizes DNA structure.
Surrounding the core is the cortex, a thick layer composed primarily of peptidoglycan, the same material found in bacterial cell walls. However, the cortex’s peptidoglycan is more densely cross-linked, providing additional mechanical strength. During endospore germination, the cortex swells and degrades, allowing the core to rehydrate and resume metabolic activity. This process is tightly regulated, ensuring that germination occurs only under favorable conditions. For researchers studying spore revival, maintaining a humid environment (relative humidity >90%) and temperatures above 30°C are optimal for triggering this transition.
Encasing the cortex are multiple protective layers, each contributing to the endospore’s durability. The outermost layer, the exosporium, is a proteinaceous coat that acts as a barrier against physical and chemical stressors. Beneath it lies the coat layer, composed of over 70 proteins arranged in a crystalline structure, which provides further protection against enzymes and environmental toxins. In some Bacillus species, an additional layer called the spore coat contains keratin-like proteins, enhancing resistance to heat and UV radiation. These layers collectively enable endospores to survive temperatures exceeding 100°C, exposure to radiation, and prolonged desiccation.
Practical applications of endospore structure knowledge are vast. In the food industry, understanding how endospores resist heat informs sterilization techniques like autoclaving, which requires temperatures of 121°C for 15-20 minutes to ensure spore destruction. In biotechnology, endospores are used as vectors for delivering enzymes or vaccines due to their stability. For hobbyists or educators culturing Bacillus species, avoiding temperatures below 60°C during sterilization ensures spores remain viable for study. By dissecting the endospore’s architecture, we not only appreciate its complexity but also harness its potential for innovation and problem-solving.
Heat's Role in Spore Staining: Enhancing Accuracy and Visualization
You may want to see also

Endospore Function: Endospores ensure bacterial survival in harsh conditions like heat and drought
Bacillus species are renowned for their ability to form endospores, a dormant, highly resistant structure that ensures survival in extreme environments. These endospores are not just a passive defense mechanism but a sophisticated adaptation that allows bacteria to endure conditions that would otherwise be lethal. When nutrients become scarce or environmental stresses like heat, drought, or radiation intensify, Bacillus cells initiate endospore formation, a process known as sporulation. This transformation involves the creation of a thick, protective spore coat and the dehydration of the cell’s contents, rendering it metabolically inactive yet remarkably resilient.
Consider the practical implications of this survival strategy. In agriculture, Bacillus endospores are used in biofertilizers and biopesticides because they can withstand harsh soil conditions, ensuring long-term efficacy. For instance, *Bacillus thuringiensis* endospores remain viable in dry, sun-exposed fields, ready to activate and produce toxins that target pests when conditions improve. Similarly, in food preservation, endospores of *Bacillus subtilis* can survive pasteurization temperatures (typically 63°C for 30 minutes), highlighting the need for more stringent sterilization methods like autoclaving (121°C for 15 minutes) to ensure food safety.
From an analytical perspective, the endospore’s structure is key to its function. The multilayered spore coat, composed of keratin-like proteins, provides resistance to heat, desiccation, and chemicals. Beneath this lies the cortex, a peptidoglycan layer that protects against physical and enzymatic damage. The core, containing the bacterial genome and minimal cytoplasm, is dehydrated to a water content of 20–30%, further enhancing resistance. This design allows endospores to survive for decades, even centuries, in environments where active bacterial cells would perish within minutes.
To harness the power of endospores, industries must consider their activation. Endospores are metabolically dormant and cannot be killed by standard disinfectants or antibiotics. However, they can be activated by specific triggers, such as nutrient availability and temperature shifts. For example, in wastewater treatment, *Bacillus* endospores are used to degrade organic matter; activation occurs when the spores encounter favorable conditions in the treatment plant. Understanding these activation mechanisms is crucial for both utilizing and controlling endospore-forming bacteria in various applications.
In conclusion, the endospore function in Bacillus species is a testament to bacterial ingenuity in surviving harsh conditions. Whether in heat, drought, or other extremes, endospores provide a fail-safe mechanism that ensures the persistence of these microorganisms. By studying their structure, resistance, and activation, we can both leverage their benefits in biotechnology and develop strategies to mitigate their risks in food safety and healthcare. This dual perspective underscores the importance of understanding endospores as a unique and powerful bacterial survival tool.
Exploring the Spore Druid's Wild Shape Abilities and Limitations
You may want to see also
Explore related products

Endospore Germination: Endospores return to vegetative state when favorable conditions return
Bacillus species are renowned for their ability to form endospores, a dormant, highly resistant structure that allows them to survive extreme conditions such as heat, desiccation, and radiation. These endospores are not just a passive survival mechanism; they are a dynamic system that can revert to an active, vegetative state when environmental conditions improve. This process, known as endospore germination, is a critical phase in the life cycle of Bacillus, ensuring their persistence and proliferation in diverse ecosystems.
Triggering Germination: The Role of Nutrients and Signals
Endospore germination is initiated by specific triggers, primarily the presence of nutrients like amino acids, purine bases, and certain sugars. For instance, L-valine and inosine are well-documented germinants for Bacillus subtilis, acting as signals that favorable conditions have returned. The process begins with the activation of receptors on the endospore’s outer layers, leading to the release of dipicolinic acid (DPA), a calcium-bound molecule that stabilizes the endospore’s structure. As DPA levels decrease, the endospore’s core rehydrates, and metabolic activity resumes. Practical applications of this knowledge include using specific germinants in laboratory settings to study Bacillus or in industrial processes where controlled germination is required.
Steps in Endospore Germination: A Sequential Revival
Germination occurs in stages, starting with the uptake of germinants, followed by the release of DPA and core hydration. The cortex layer, composed of modified peptidoglycan, is then degraded by enzymes like cortex lytic enzymes (CLEs), allowing water to penetrate further. Finally, the endospore’s protective coats are shed, and the cell resumes metabolic activity, transitioning into a vegetative state. This process is highly regulated, ensuring energy efficiency and minimizing damage during revival. For example, in food preservation, understanding these steps can help design strategies to prevent unwanted germination of Bacillus endospores, which are notorious for spoilage and contamination.
Comparative Advantage: Why Endospore Germination Matters
Compared to other bacterial survival strategies, endospore germination offers Bacillus a unique edge. While many bacteria rely on biofilm formation or sporulation, endospores provide unparalleled durability and the ability to remain viable for centuries. This makes Bacillus species dominant in environments prone to fluctuating conditions, such as soil and water. In medical contexts, understanding germination can inform strategies to combat Bacillus infections, as germinated spores are more susceptible to antibiotics than dormant ones. For instance, combining germinants with antibiotics could enhance treatment efficacy for Bacillus anthracis, the causative agent of anthrax.
Practical Tips for Controlling Endospore Germination
In industrial and clinical settings, controlling endospore germination is crucial. Sterilization processes, such as autoclaving at 121°C for 15–20 minutes, are designed to destroy endospores before they can germinate. However, in cases where germination is desired, such as in biotechnology, specific germinants can be applied under controlled conditions. For home preservation, ensuring food is stored at low temperatures (below 4°C) can prevent germination, as most Bacillus species require temperatures above 20°C to initiate the process. Additionally, pH levels below 4.5 can inhibit germination, making acidic environments hostile to Bacillus endospores.
By understanding the mechanisms and triggers of endospore germination, we can harness this process for beneficial applications while mitigating risks in food safety, healthcare, and environmental management. Whether in the lab or the field, this knowledge empowers us to control one of nature’s most resilient survival strategies.
Can Asteroids Collide with Planets in Spore? Exploring the Possibility
You may want to see also

Bacillus Species Variation: Not all Bacillus species produce endospores; depends on the strain
Bacillus species are renowned for their resilience, largely attributed to their ability to form endospores—dormant, highly resistant structures that enable survival in harsh conditions. However, this trait is not universal across the genus. While species like *Bacillus anthracis* and *Bacillus subtilis* are well-documented endospore producers, others such as *Bacillus cereus* exhibit variability, with some strains forming endospores and others remaining vegetative. This variation underscores the importance of strain-specific identification in microbiological studies and applications.
To understand this diversity, consider the environmental niches Bacillus species inhabit. Endospore formation is an adaptive response to stress, such as nutrient depletion or extreme temperatures. Strains isolated from stable, resource-rich environments may lack this ability, as they have no evolutionary pressure to develop it. For instance, *Bacillus coagulans*, often found in fermented foods, rarely forms endospores under typical conditions. In contrast, soil-dwelling strains like *Bacillus pumilus* consistently produce endospores to endure fluctuating conditions. This ecological context highlights how habitat shapes microbial traits.
Practical implications of this variation are significant, particularly in biotechnology and medicine. Endospore-forming strains are favored for industrial applications, such as enzyme production or bioremediation, due to their robustness. For example, *Bacillus subtilis* spores are used in probiotics for their ability to withstand gastric acids. However, non-endospore-forming strains like certain *Bacillus cereus* isolates are employed in food fermentation, where vegetative growth is desirable. Misidentification of strains can lead to inefficiencies or safety risks, emphasizing the need for precise strain characterization.
From a laboratory perspective, distinguishing endospore-producing from non-producing strains requires specific techniques. Heat treatment at 80°C for 10 minutes can differentiate spores from vegetative cells, as spores survive while vegetative cells are inactivated. Microscopy with malachite green staining further confirms spore presence. Researchers and practitioners must employ these methods to accurately classify Bacillus strains, ensuring appropriate use in experiments or applications.
In conclusion, the variability in endospore production among Bacillus species is a critical yet often overlooked aspect of their biology. Understanding this trait at the strain level is essential for leveraging Bacillus in various fields, from industry to healthcare. By recognizing the ecological and practical implications of this variation, scientists can make informed decisions, optimizing the use of these versatile microorganisms.
Snake Plants and Mold: Do They Absorb Spores Effectively?
You may want to see also
Frequently asked questions
Yes, Bacillus is a genus of bacteria known for its ability to form highly resistant endospores under unfavorable environmental conditions.
Bacillus endospores are dormant, tough, and non-reproductive structures that allow the bacteria to survive extreme conditions like heat, radiation, and desiccation. They are important for the bacterium's long-term survival and dispersal.
While most Bacillus species are capable of forming endospores, there are a few exceptions. However, the majority of well-known Bacillus species, such as Bacillus anthracis and Bacillus subtilis, are endospore-forming.































